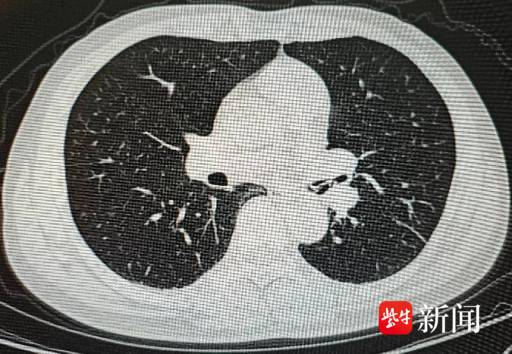

太惊险!春节聚餐六旬男子吃鱼卡喉,支气管多处鱼骨嵌顿
来源: 紫牛新闻
2026-02-19 16:07:00
春节家人团聚,聚餐吃饭本是开心事,但一不小心,也可能暗藏风险。2026年2月18日(正月初二),安徽60多岁的李先生(化名),就在家庭聚餐后遭遇了一场惊魂时刻。
当天聚餐后,李先生突然出现严重咳嗽症状,当地医院检查后发现,其气道内有高密度异物,情况不容乐观,随即紧急转往江苏省人民医院(南京医科大学第一附属医院、江苏省妇幼保健院)急诊求助。急诊紧急联系呼吸与危重症医学科值班医生进行会诊。
此时正值春节假期,呼吸与危重症医学科朱毅副主任医师和李君兰护师,得知有急诊患者需要救治后,第一时间赶往医院。抵达医院后,朱毅副主任医师对李先生的病情进行了仔细评估,考虑到异物嵌顿气道可能危及生命,决定立即为其实施手术。

手术过程中,医护人员发现,李先生左主支气管远端有一枚巨大且尖锐的骨样异物,已经嵌顿进支气管管壁,周围还有密集的血管,稍有不慎就可能引发危险。朱毅副主任医师凭借丰富的临床经验和仔细小心操作,成功将这枚异物取出。
令人意外的是,手术中还发现,李先生左上叶、左下叶开口等处,还同时另有三枚尖锐的骨样异物嵌顿,朱毅副主任医师逐一小心将其取出。术后经确认,这些嵌顿的异物均为锐利的鱼刺。
据李先生回忆,春节期间聚餐时食用昂刺鱼,不慎将鱼骨呛入气道,当时并未太在意,直到出现严重咳嗽才意识到问题的严重性。目前,李先生术后恢复良好,已无大碍。
此次救治过程中,从患者接诊、紧急会诊,到手术顺利实施,我院春节假期救治环节衔接顺畅,更体现了我院呼吸与危重症医学科团队对疑难危重患者的及时响应和认真处置。值得关注的是,当时李君兰护师正在外地,其爱人主动承担起接送任务,往返驱车四个多小时,确保她能及时到岗参与救治,谱写一曲“并肩作战,共筑生命防线”新篇章。
在此医生也提醒大家,春节聚餐食用鱼类等带骨食物时,一定要细嚼慢咽,格外小心,避免异物呛入气道。若不慎发生异物呛入,出现咳嗽、呼吸困难等症状,切勿盲目处理,应及时前往医院就诊,以免延误治疗。
通讯员 吴超杰 姚欣
扬子晚报/紫牛新闻记者 吕彦霖